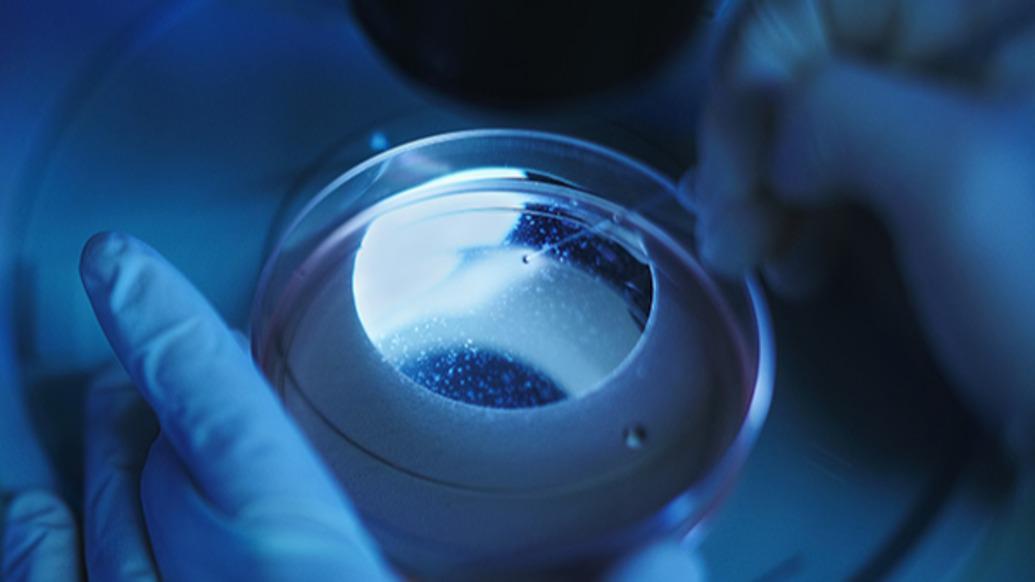
微塑料危机被夸大？科学界质疑“人体微塑料水平大幅上升只是实验误差”

四川美丰最新股价报6.95元,较前一交易日上涨0.02元,涨幅0.29%。盘中最高触及6.96元,最低6.91元,成交金额0.36亿元。
该公司主营业务涵盖化学肥料制造、天然气供应等领域,2024年财报显示其化肥业务占总营收46.05%。企业注册地位于四川省德阳市,目前总市值38.84亿元。
6月9日公司召开第十届董事会第二十五次会议,审议通过了包括董事会换届选举在内的多项议案。根据公告,公司将于6月26日召开2025年第二次临时股东会,主要议程包括审议新一届董事会成员人选及公司章程修订等事项。
当日主力资金净流出689.24万元,占流通市值比例0.18%。
风险提示:投资有风险,入市需谨慎。

京公网安备 11011402013531号